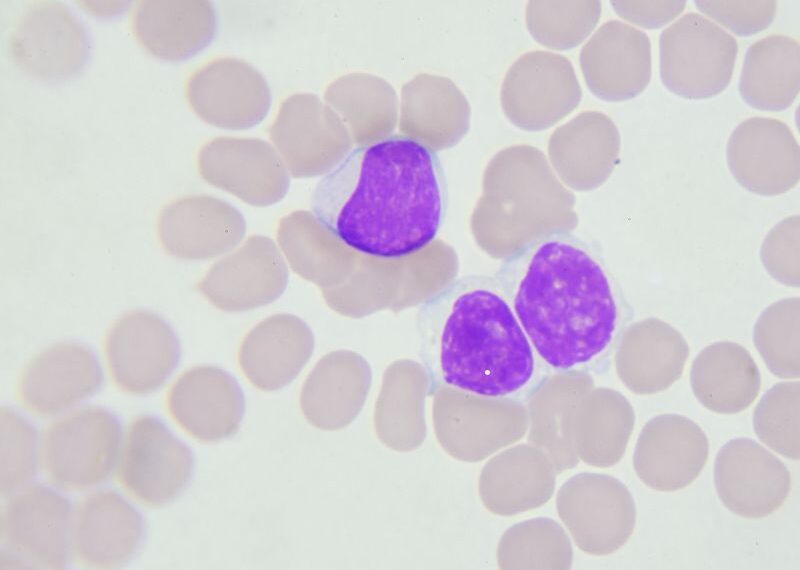

Cos’è la mitosi e qual è il suo ruolo nel ciclo cellulare
La mitosi è un processo cruciale nel ciclo di vita di ogni cellula, essenziale per la crescita e la rigenerazione dei tessuti. Durante questa fase, la cellula duplica il proprio materiale genetico e lo distribuisce equamente tra due cellule figlie, assicurando la continuità del codice genetico. Se qualcosa va storto, la cellula attiva meccanismi di autodistruzione o di blocco della crescita, evitando così la propagazione di errori. Nei tumori del sangue, però, questo meccanismo può essere compromesso, favorendo la crescita incontrollata delle cellule cancerogene.
Come funziona la divisione cellulare
La mitosi non è solo una duplicazione del DNA, ma un complesso processo che coinvolge diverse strutture cellulari. I centrosomi, proteine che agiscono come “ancore” per il materiale genetico, si posizionano ai poli opposti della cellula per garantire che il DNA duplicato sia distribuito correttamente. Quando il processo si svolge correttamente, nascono due cellule sane; ma se i centrosomi sono presenti in numero anomalo, la cellula rischia di diventare disfunzionale e, in alcuni casi, maligna. Molte cellule tumorali presentano infatti un numero eccessivo di centrosomi, caratteristica che aumenta la loro instabilità genetica.

In cosa consiste la nuova scoperta contro i tumori del sangue
Un gruppo di ricercatori guidato da Andreas Villunger (ricercatore al CeMM di Vienna e professore all’Università di Medicina di Innsbruck) e Luca Fava (professore associato del Dipartimento di Biologia cellulare, computazionale e integrata – Dip. Cibio dell’Università di Trento) ha scoperto un meccanismo molecolare che induce la morte delle cellule tumorali con un doppio attacco. La presenza di centrioma sovrannumero innesca un complesso proteico chiamato PIDDosoma, che attiva l’enzima caspasi-2. Questo enzima attiva due percorsi distinti: uno in cui la proteina BID distrugge i mitocondri, le “centrali energetiche” della cellula, e un altro in cui il soppressore tumorale p53 avvia segnali di autodistruzione. Grazie a questo meccanismo, anche se una delle proteine (BID o p53) è assente o inattiva, la cellula tumorale può essere eliminata. I risultati dello studio sono stati pubblicati sulla rivista Science Advances.
Qual è la svolta nella ricerca contro i tumori del sangue
Questa scoperta rappresenta una potenziale svolta per le terapie contro i tumori del sangue. Le cellule tumorali si dividono frequentemente e tendono ad accumulare un numero elevato di centrosomi, rendendole vulnerabili a questo doppio attacco. Le attuali terapie mirano già a interferire con la divisione cellulare delle cellule cancerose, ma il rafforzamento del meccanismo del PIDDosoma potrebbe aumentarne l’efficacia. Grazie a questa nuova strategia, si potrebbe migliorare la capacità delle terapie di eliminare selettivamente le cellule maligne, aprendo nuove prospettive per trattamenti più mirati e potenti.